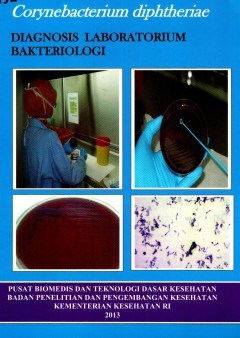
cover

Ditapis dengan
# Debug Box
/var/www/perpustakaan972/lib/SearchEngine/DefaultEngine.php:610 "Search Engine Debug 🔎 🪲"
Engine Type ⚙️: "SLiMS\SearchEngine\DefaultEngine"
SQL ⚙️: array:2 [ "count" => "select count(distinct b.biblio_id) from biblio as b left join mst_publisher as mp on b.publisher_id=mp.publisher_id left join mst_place as mpl on b.publish_place_id=mpl.place_id where b.opac_hide=0 and (b.biblio_id in(select bt.biblio_id from biblio_topic as bt left join mst_topic as mt on bt.topic_id=mt.topic_id where mt.topic like ?))" "query" => "select b.biblio_id, b.title, b.image, b.isbn_issn, b.publish_year, mp.publisher_name as `publisher`, mpl.place_name as `publish_place`, b.labels, b.input_date, b.edition, b.collation, b.series_title, b.call_number from biblio as b left join mst_publisher as mp on b.publisher_id=mp.publisher_id left join mst_place as mpl on b.publish_place_id=mpl.place_id where b.opac_hide=0 and (b.biblio_id in(select bt.biblio_id from biblio_topic as bt left join mst_topic as mt on bt.topic_id=mt.topic_id where mt.topic like ?)) order by b.last_update desc limit 10 offset 0" ]
Bind Value ⚒️: array:1 [ 0 => "%BACTERIOLOGY%" ]
Mycology & bacteriology
- Edisi
- -
- ISBN/ISSN
- 978-38473-019-4
- Deskripsi Fisik
- 574 p.; bibl, ilus.; 22 cm.
- Judul Seri
- -
- No. Panggil
- QW 4 SHR 2011
- Edisi
- -
- ISBN/ISSN
- 978-38473-019-4
- Deskripsi Fisik
- 574 p.; bibl, ilus.; 22 cm.
- Judul Seri
- -
- No. Panggil
- QW 4 SHR 2011

Comprehensive Review of Infectious Diseases
- Edisi
- -
- ISBN/ISSN
- 978-0-323-56866-1
- Deskripsi Fisik
- xviii, 758 hlm. : illus.; 29 cm
- Judul Seri
- -
- No. Panggil
- WC 100 SPE 2020
- Edisi
- -
- ISBN/ISSN
- 978-0-323-56866-1
- Deskripsi Fisik
- xviii, 758 hlm. : illus.; 29 cm
- Judul Seri
- -
- No. Panggil
- WC 100 SPE 2020
Corynebacterium Diphtheriae : Diagnosis Laboratorium Bakteriologi
- Edisi
- -
- ISBN/ISSN
- 918-3-16-148410-0
- Deskripsi Fisik
- 70p.; bibl.; ilus.; 30 cm.
- Judul Seri
- -
- No. Panggil
- WC 318 RUD 2013
- Edisi
- -
- ISBN/ISSN
- 918-3-16-148410-0
- Deskripsi Fisik
- 70p.; bibl.; ilus.; 30 cm.
- Judul Seri
- -
- No. Panggil
- WC 318 RUD 2013

Bacteriological Test Quality of Food in Polytechnic of Health Jakarta II Campus
Based Kepmenkes No. 1098/Menkes/SK/VII/2003 on Hygiene Sanitation Requirements for food vendors and Restaurant, that the minuman content of Excherichia coli (E.coli) is 0 gram.Insouth of Jakarta 2002, food contamination by E. Coli by 58.3% and 37% respectively in lemper and arem-arem. 2003 in South Jakarta, was also found cooked food contaminated with colfrom presence of 45.1%, by E. Coli 31.8%…
- Edisi
- -
- ISBN/ISSN
- 1978-8843
- Deskripsi Fisik
- 5p.
- Judul Seri
- -
- No. Panggil
- Sanitas, 5(2)2011:1029-1034

Identifikasi bakteriologi air pada peralatan makan minum di warung/restoran d…
- Edisi
- -
- ISBN/ISSN
- -
- Deskripsi Fisik
- 29 p.
- Judul Seri
- -
- No. Panggil
- 84 LIT
- Edisi
- -
- ISBN/ISSN
- -
- Deskripsi Fisik
- 29 p.
- Judul Seri
- -
- No. Panggil
- 84 LIT

Hubungan Kualitas Bakteriologis Peralatan Makan dengan Kejadian Diare di Pusk…
The incident of diarrhea found in communiy still quite high and mortality due to diarrhea take bigger part on cause of death in Indonesia. To evaluate the relation between Escherichia coli bacteriological quality of infant utensil of eating, enviroment risk factor and other risk factor with incident of infant diarrhea disease within working area of Puskesmas Sukaresmi at Cianjur District, Provi…
- Edisi
- -
- ISBN/ISSN
- 0216-0910
- Deskripsi Fisik
- 6p.
- Judul Seri
- -
- No. Panggil
- Medika, 34(): 396-403

Perbedaan Kualitas Bakteriologis Air Sumur Gali dan Kejadian Diare pada Daera…
Diare merupakan salah satu penyakit berbasis lingkungan yan masih menjadi masalah kesehatan di Negara-negara berkembang. Dua factor dominan yang menyebabkan terjadinya diare yaitu sarana air bersih dan pembuangan tinja. Dampak yang ditimbulkan dengan adanya rob salah satunya adalah tercemarnya sarana abersih di masyarakat yaitu sumur gali. Incidence rate diare di Kelurahan Rejomulyo tahun 2007 …
- Edisi
- -
- ISBN/ISSN
- 142-4920
- Deskripsi Fisik
- 7p.
- Judul Seri
- -
- No. Panggil
- Media Kesehatan Masyarakat Indonesia, 7(1): 19-25

Kejaian Bakteriologis pada Sistem Penyediaa Air Bersih di Komplek Akademi Kep…
There were still water born diseases occurred in Police Academy like Morbili, Variola, Thypus, Conjunctivitis, Diarea Varicella, Herpes and DHF. Overall cases had the amount of 136 (in the year 2005) and 241 (in the year 2006) Those diseases may be related to the bacteriological quality of water. This research aimed to study the bacteriological quality on water supply system in Police Academy S…
- Edisi
- -
- ISBN/ISSN
- 1421-4920
- Deskripsi Fisik
- 6p.
- Judul Seri
- -
- No. Panggil
- Media Kesehatan Masyarakat Indonesia, 7(1): 35-40

Bergey's Manual of Determinative Bacteriology
- Edisi
- 9 th ed
- ISBN/ISSN
- 978 0 683 006003 2
- Deskripsi Fisik
- 787 p.; Bibl; 28 cm; Ilus
- Judul Seri
- -
- No. Panggil
- QW 1 HOL 2000
- Edisi
- 9 th ed
- ISBN/ISSN
- 978 0 683 006003 2
- Deskripsi Fisik
- 787 p.; Bibl; 28 cm; Ilus
- Judul Seri
- -
- No. Panggil
- QW 1 HOL 2000
Review of Medical Microbiology and Immunology
- Edisi
- -
- ISBN/ISSN
- 978-007-128177-5
- Deskripsi Fisik
- 672 p.; bibl, ilus; 24 cm
- Judul Seri
- -
- No. Panggil
- QW 501 LEV 2008
- Edisi
- -
- ISBN/ISSN
- 978-007-128177-5
- Deskripsi Fisik
- 672 p.; bibl, ilus; 24 cm
- Judul Seri
- -
- No. Panggil
- QW 501 LEV 2008
 Karya Umum
Karya Umum  Filsafat
Filsafat  Agama
Agama  Ilmu-ilmu Sosial
Ilmu-ilmu Sosial  Bahasa
Bahasa  Ilmu-ilmu Murni
Ilmu-ilmu Murni  Ilmu-ilmu Terapan
Ilmu-ilmu Terapan  Kesenian, Hiburan, dan Olahraga
Kesenian, Hiburan, dan Olahraga  Kesusastraan
Kesusastraan  Geografi dan Sejarah
Geografi dan Sejarah